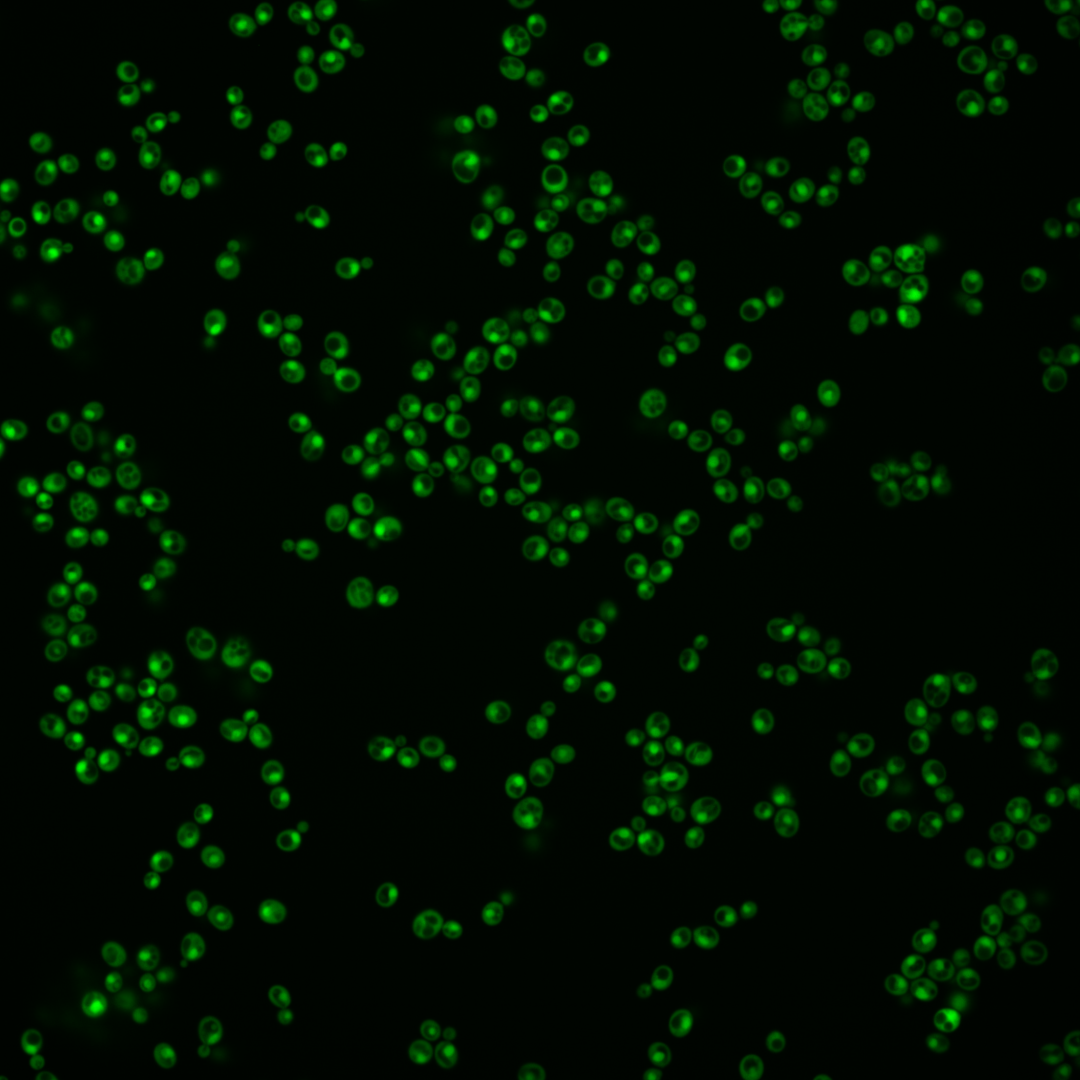
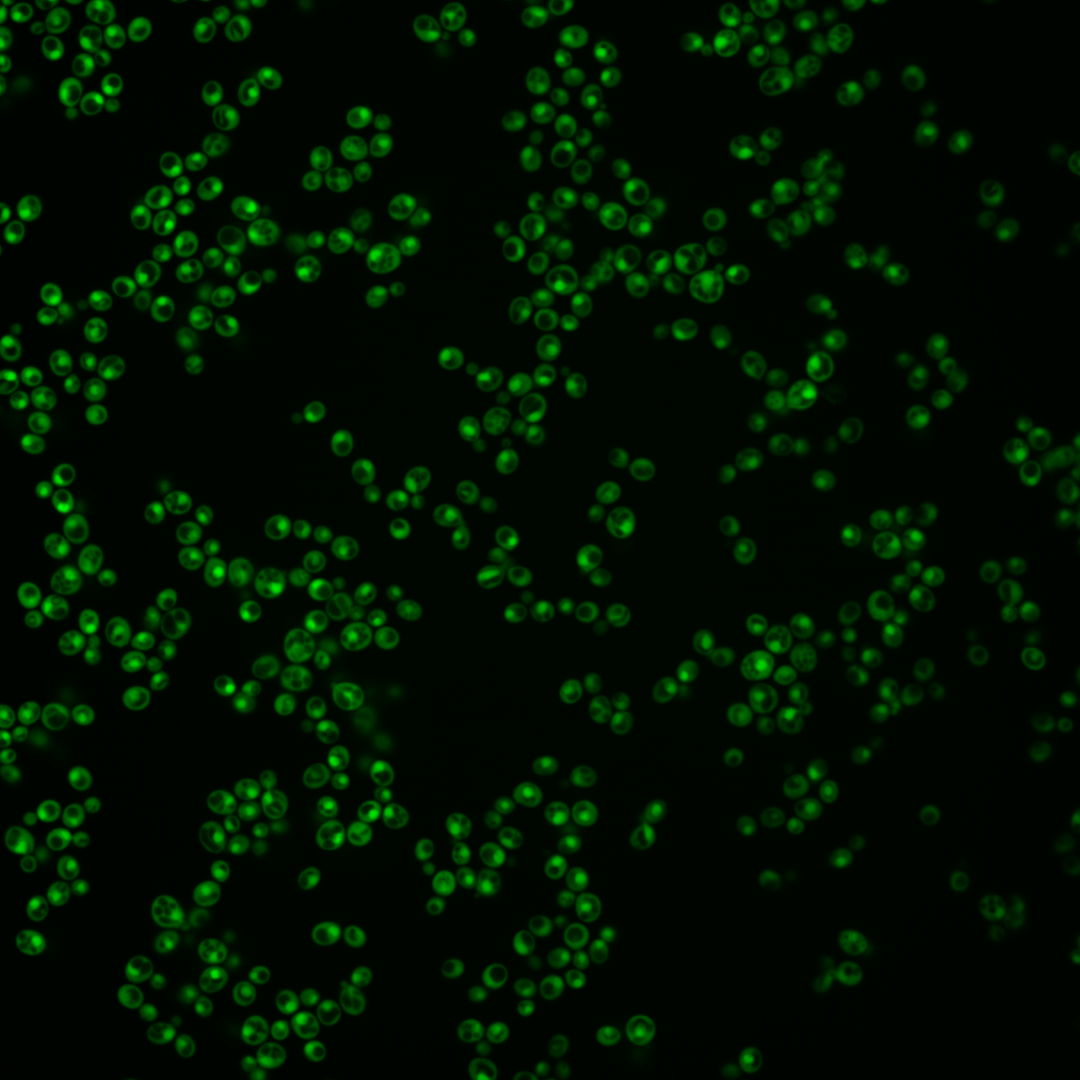
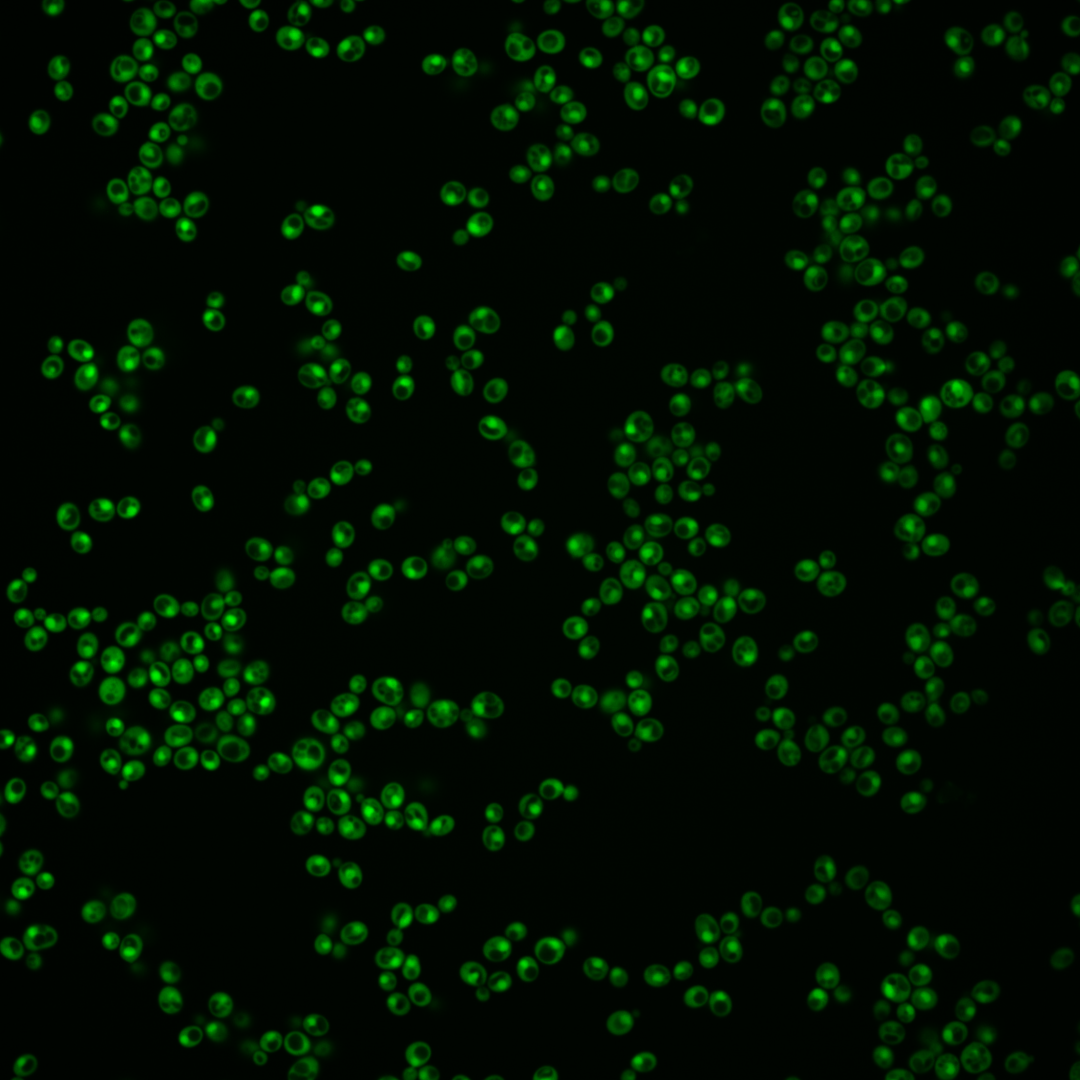
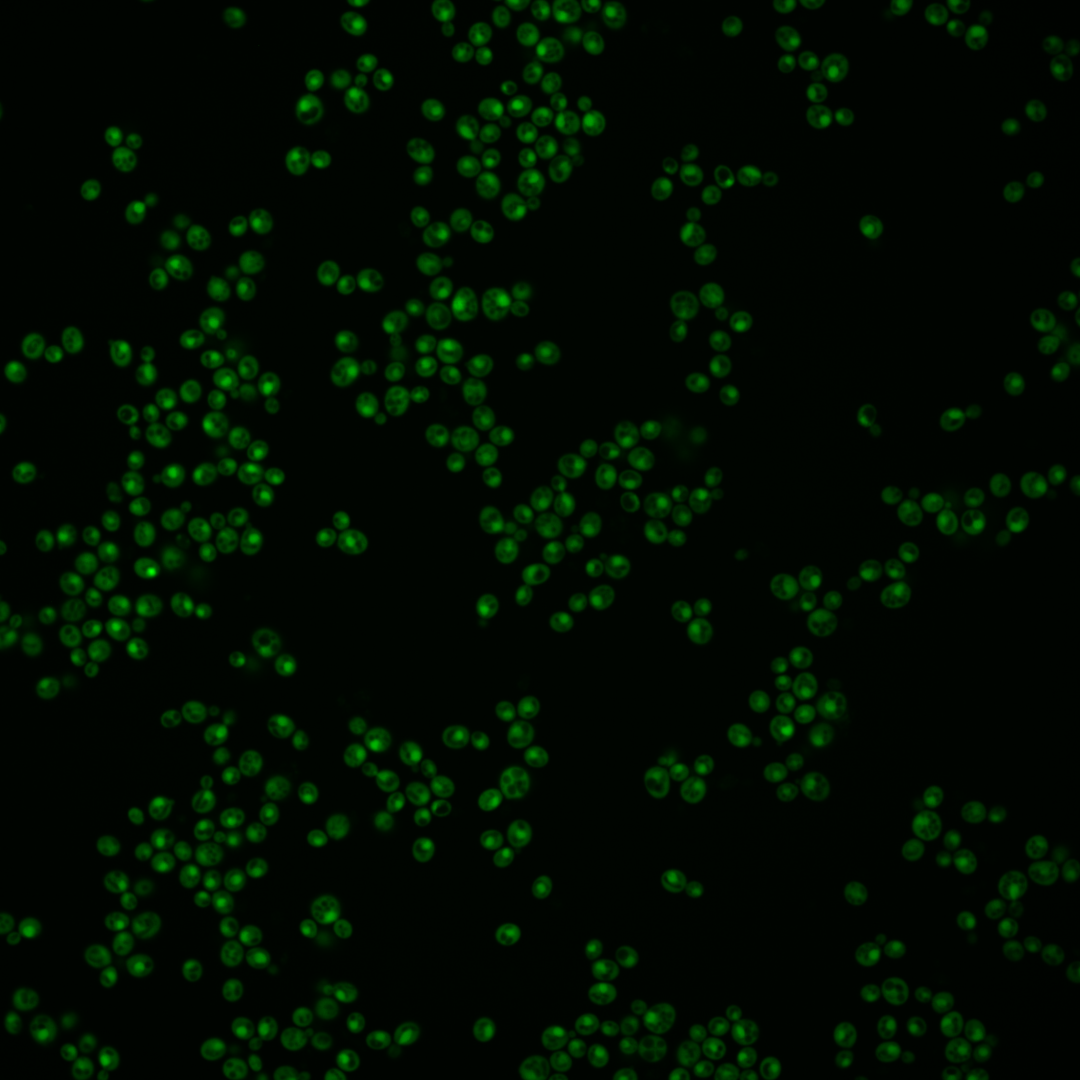
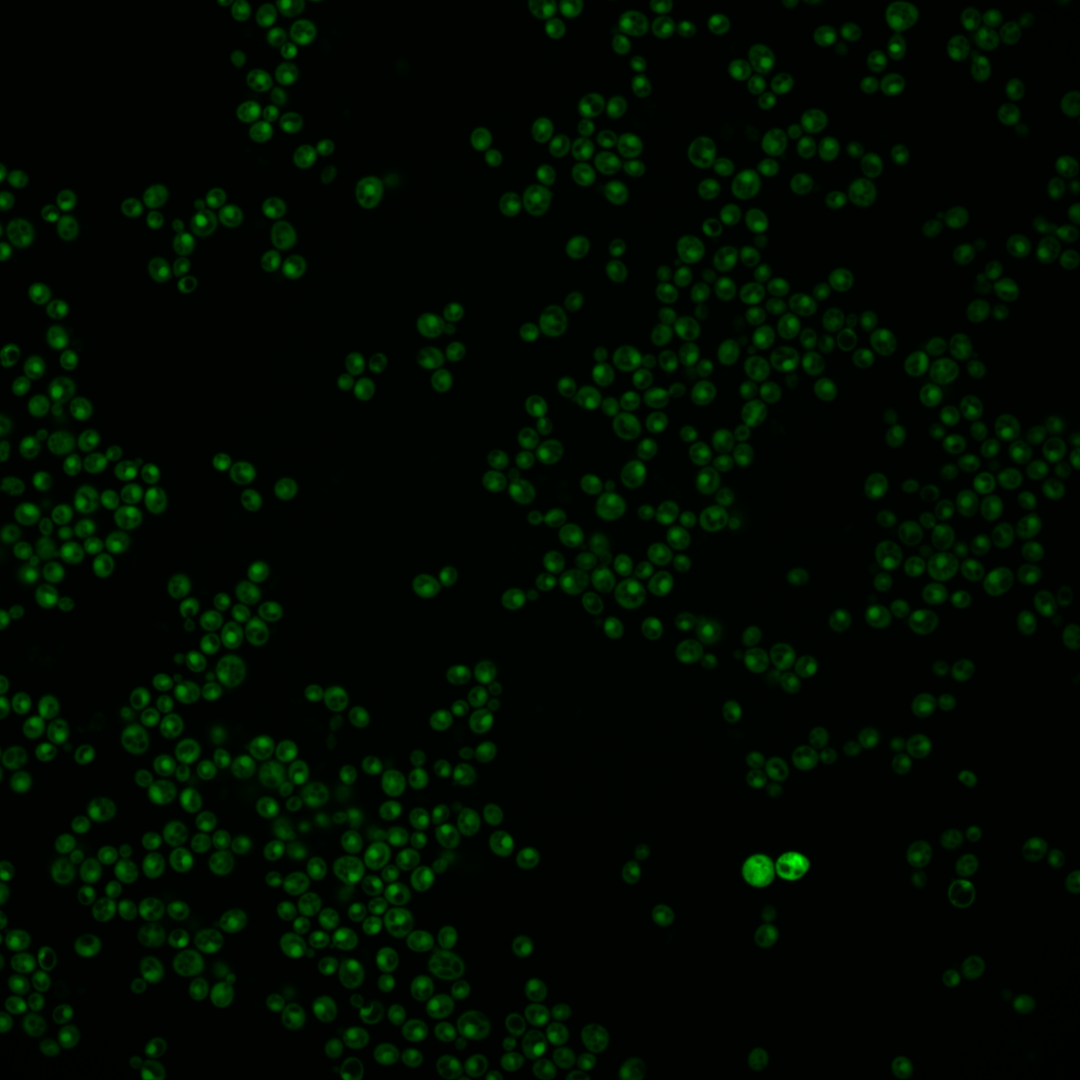
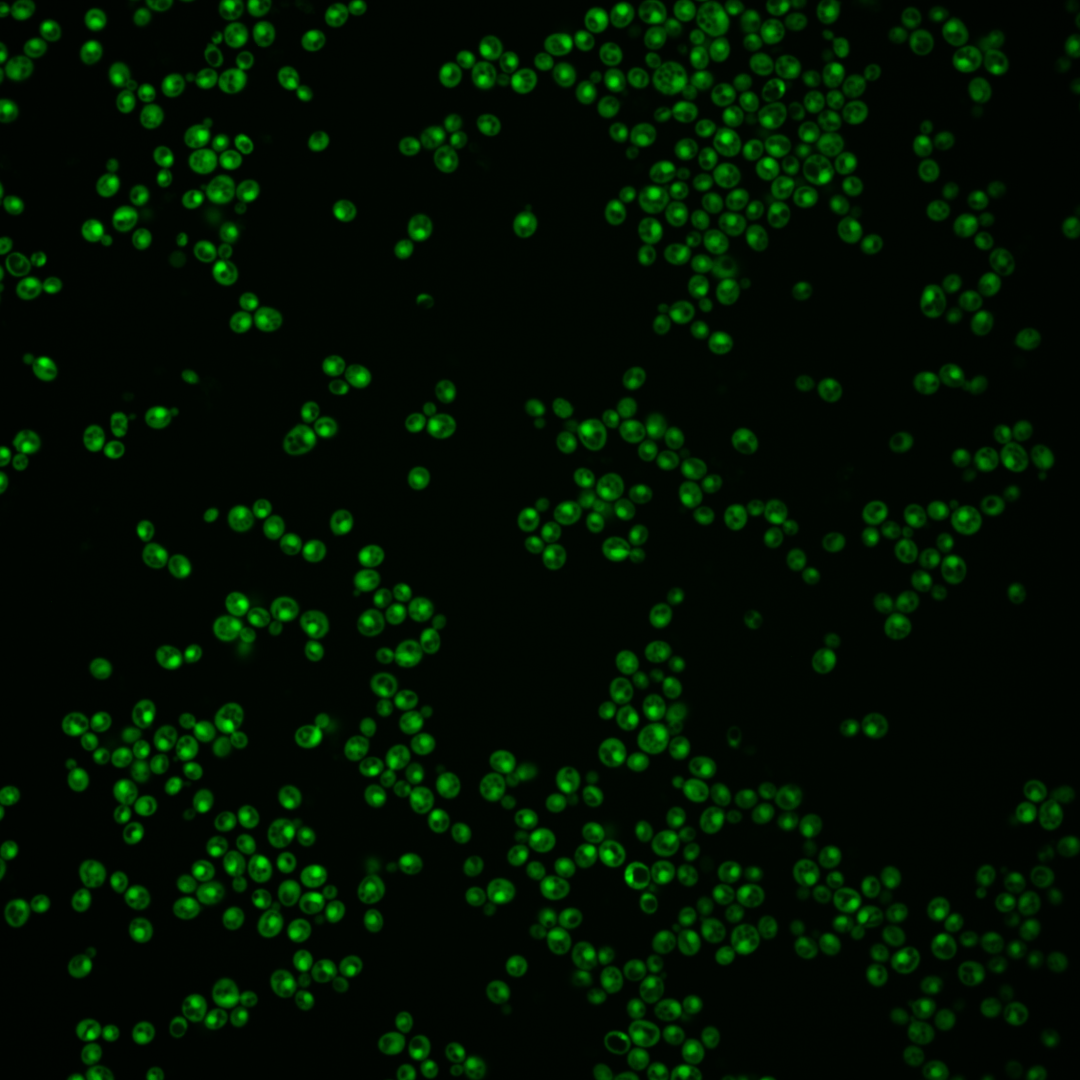
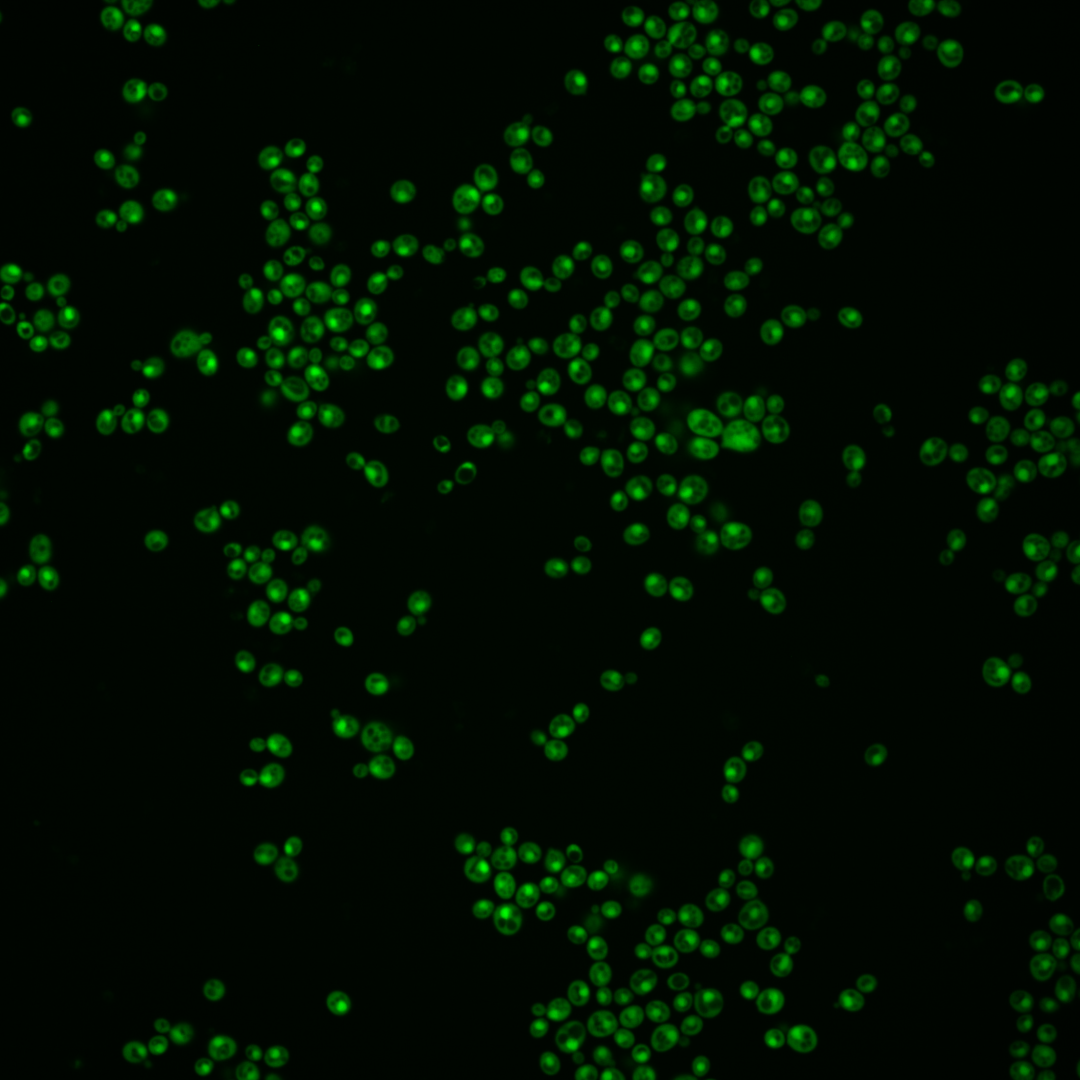

| Standard name | |
|---|---|
| Human Ortholog | |
| Description | Ubiquitin activating enzyme (E1); involved in ubiquitin-mediated protein degradation and essential for viability; protein abundance increases in response to DNA replication stress |
Micrographs




















































































Sub-cellular Localization
Yeast GFP Assignment
Protein Abundance
Localization Change
External localization resources
| ensLOC | DeepLoc | |||||||||||||||||||||||
|---|---|---|---|---|---|---|---|---|---|---|---|---|---|---|---|---|---|---|---|---|---|---|---|---|
| Localization | WT1 | WT2 | WT3 | RAP60 | RAP140 | RAP220 | RAP300 | RAP380 | RAP460 | RAP540 | RAP620 | RAP700 | HU80 | HU120 | HU160 | rpd3Δ_1 | rpd3Δ_2 | rpd3Δ_3 | WT1 | WT2 | WT3 | AF100 | AF140 | AF180 |
| Cortical Patches | 0 | 0 | 0 | 0 | 1 | 2 | 5 | 3 | 3 | 4 | 12 | 11 | 0 | 0 | 1 | 0 | 0 | 0 | 0 | 0 | 0 | 0 | 0 | 1 |
| Bud | 0 | 0 | 0 | 0 | 0 | 0 | 1 | 2 | 2 | 0 | 1 | 0 | 0 | 2 | 1 | 0 | 0 | 0 | 4 | 12 | 7 | 17 | 9 | 13 |
| Bud Neck | 0 | 0 | 0 | 0 | 0 | 0 | 0 | 0 | 0 | 0 | 0 | 0 | 0 | 0 | 0 | 0 | 0 | 0 | 0 | 0 | 0 | 0 | 0 | 0 |
| Bud Site | 0 | 0 | 0 | 0 | 0 | 0 | 0 | 0 | 0 | 0 | 0 | 0 | 0 | 0 | 0 | 0 | 0 | 0 | – | – | – | – | – | – |
| Cell Periphery | 0 | 0 | 0 | 1 | 1 | 2 | 2 | 4 | 4 | 5 | 13 | 8 | 0 | 1 | 0 | 5 | 1 | 1 | 0 | 0 | 0 | 0 | 0 | 0 |
| Cytoplasm | 118 | 184 | 294 | 195 | 315 | 351 | 455 | 353 | 287 | 342 | 245 | 256 | 271 | 346 | 400 | 456 | 262 | 335 | 70 | 92 | 252 | 57 | 80 | 66 |
| Endoplasmic Reticulum | 5 | 1 | 3 | 6 | 19 | 16 | 37 | 30 | 17 | 21 | 18 | 10 | 1 | 9 | 12 | 23 | 8 | 15 | 0 | 1 | 4 | 4 | 5 | 7 |
| Endosome | 0 | 0 | 0 | 0 | 0 | 0 | 0 | 0 | 0 | 0 | 0 | 0 | 0 | 0 | 0 | 0 | 0 | 0 | 0 | 1 | 6 | 1 | 2 | 3 |
| Golgi | 0 | 4 | 13 | 12 | 16 | 1 | 6 | 20 | 5 | 6 | 14 | 6 | 3 | 2 | 1 | 4 | 3 | 6 | 0 | 0 | 0 | 0 | 0 | 0 |
| Mitochondria | 0 | 1 | 0 | 1 | 0 | 0 | 0 | 4 | 8 | 20 | 18 | 14 | 1 | 0 | 0 | 0 | 0 | 0 | 0 | 0 | 0 | 0 | 0 | 0 |
| Nucleus | 5 | 4 | 4 | 5 | 4 | 2 | 15 | 12 | 8 | 14 | 13 | 11 | 3 | 2 | 0 | 1 | 1 | 0 | 94 | 186 | 237 | 116 | 79 | 108 |
| Nuclear Periphery | 0 | 0 | 0 | 0 | 0 | 0 | 0 | 0 | 0 | 0 | 0 | 0 | 0 | 0 | 0 | 0 | 0 | 0 | 1 | 2 | 5 | 2 | 5 | 3 |
| Nucleolus | 1 | 4 | 1 | 0 | 1 | 1 | 1 | 3 | 7 | 3 | 2 | 2 | 0 | 0 | 0 | 0 | 0 | 0 | 0 | 1 | 1 | 1 | 2 | 5 |
| Peroxisomes | 0 | 0 | 0 | 0 | 0 | 0 | 0 | 0 | 0 | 0 | 0 | 0 | 0 | 0 | 0 | 0 | 0 | 0 | 0 | 0 | 0 | 0 | 0 | 0 |
| SpindlePole | 0 | 0 | 0 | 0 | 0 | 0 | 0 | 0 | 0 | 0 | 0 | 0 | 0 | 0 | 0 | 0 | 0 | 0 | 1 | 4 | 2 | 1 | 1 | 3 |
| Vac/Vac Membrane | 26 | 109 | 198 | 60 | 54 | 15 | 32 | 35 | 26 | 27 | 25 | 34 | 54 | 51 | 32 | 48 | 36 | 13 | 9 | 39 | 106 | 37 | 45 | 60 |
| Unique Cell Count | 144 | 268 | 456 | 262 | 384 | 382 | 540 | 449 | 354 | 426 | 342 | 333 | 305 | 382 | 432 | 485 | 273 | 346 | 186 | 349 | 637 | 250 | 241 | 291 |
| Labelled Cell Count | 155 | 307 | 513 | 280 | 411 | 390 | 554 | 466 | 367 | 442 | 361 | 352 | 333 | 413 | 447 | 537 | 311 | 370 | 186 | 349 | 637 | 250 | 241 | 291 |
Yeast GFP Assignment
Protein Abundance
| Screen | WT1 | WT2 | WT3 | RAP60 | RAP140 | RAP220 | RAP300 | RAP380 | RAP460 | RAP540 | RAP620 | RAP700 | HU80 | HU120 | HU160 | rpd3Δ_1 | rpd3Δ_2 | rpd3Δ_3 | AF100 | AF140 | AF180 |
|---|---|---|---|---|---|---|---|---|---|---|---|---|---|---|---|---|---|---|---|---|---|
| Mean Cell GFP Intensity (1e-4) | 65.0 | 50.9 | 38.0 | 35.4 | 36.5 | 35.6 | 32.7 | 31.4 | 26.9 | 27.0 | 24.6 | 25.3 | 58.4 | 58.3 | 51.0 | 86.8 | 92.1 | 94.4 | 53.0 | 58.2 | 59.6 |
| Std Deviation (1e-4) | 12.3 | 13.6 | 8.0 | 7.7 | 8.1 | 7.4 | 7.2 | 7.6 | 6.8 | 6.9 | 6.4 | 7.1 | 15.1 | 15.1 | 14.0 | 30.1 | 32.7 | 29.9 | 15.7 | 15.7 | 19.0 |
| Intensity Change (Log2) | – | – | – | -0.1 | -0.06 | -0.1 | -0.22 | -0.28 | -0.5 | -0.49 | -0.63 | -0.59 | 0.62 | 0.62 | 0.42 | 1.19 | 1.28 | 1.31 | 0.48 | 0.61 | 0.65 |
Localization Change
| Localization | RAP60 | RAP140 | RAP220 | RAP300 | RAP380 | RAP460 | RAP540 | RAP620 | RAP700 | HU80 | HU120 | HU160 | rpd3Δ_1 | rpd3Δ_2 | rpd3Δ_3 |
|---|---|---|---|---|---|---|---|---|---|---|---|---|---|---|---|
| Cortical Patches | 0 | 0 | 0 | 0 | 0 | 0 | 0 | 4.0 | 0 | 0 | 0 | 0 | 0 | 0 | 0 |
| Bud | 0 | 0 | 0 | 0 | 0 | 0 | 0 | 0 | 0 | 0 | 0 | 0 | 0 | 0 | 0 |
| Bud Neck | 0 | 0 | 0 | 0 | 0 | 0 | 0 | 0 | 0 | 0 | 0 | 0 | 0 | 0 | 0 |
| Bud Site | 0 | 0 | 0 | 0 | 0 | 0 | 0 | 0 | 0 | 0 | 0 | 0 | 0 | 0 | 0 |
| Cell Periphery | 0 | 0 | 0 | 0 | 0 | 0 | 0 | 4.2 | 0 | 0 | 0 | 0 | 0 | 0 | 0 |
| Cytoplasm | 2.8 | 5.7 | 9.4 | 7.2 | 4.7 | 5.2 | 5.2 | 2.1 | 3.7 | 7.5 | 8.9 | 10.1 | 11.3 | 9.7 | 11.0 |
| Endoplasmic Reticulum | 0 | 3.9 | 3.4 | 5.0 | 4.8 | 3.8 | 3.9 | 4.0 | 2.6 | 0 | 2.1 | 2.5 | 3.8 | 0 | 3.5 |
| Endosome | 0 | 0 | 0 | 0 | 0 | 0 | 0 | 0 | 0 | 0 | 0 | 0 | 0 | 0 | 0 |
| Golgi | 1.2 | 1.0 | -2.9 | -2.0 | 1.3 | -1.4 | -1.5 | 1.0 | -0.9 | -1.8 | -2.5 | -3.1 | -2.3 | -1.6 | -1.0 |
| Mitochondria | 0 | 0 | 0 | 0 | 0 | 0 | 4.7 | 5.0 | 4.4 | 0 | 0 | 0 | 0 | 0 | 0 |
| Nucleus | 0 | 0 | 0 | 2.2 | 2.0 | 1.6 | 2.5 | 2.8 | 2.5 | 0 | 0 | 0 | 0 | 0 | 0 |
| Nuclear Periphery | 0 | 0 | 0 | 0 | 0 | 0 | 0 | 0 | 0 | 0 | 0 | 0 | 0 | 0 | 0 |
| Nucleolus | 0 | 0 | 0 | 0 | 0 | 0 | 0 | 0 | 0 | 0 | 0 | 0 | 0 | 0 | 0 |
| Peroxisomes | 0 | 0 | 0 | 0 | 0 | 0 | 0 | 0 | 0 | 0 | 0 | 0 | 0 | 0 | 0 |
| SpindlePole | 0 | 0 | 0 | 0 | 0 | 0 | 0 | 0 | 0 | 0 | 0 | 0 | 0 | 0 | 0 |
| Vacuole | -5.5 | -9.2 | -13.1 | -14.0 | -12.3 | -11.4 | -12.6 | -11.2 | -10.1 | -7.4 | -9.5 | -12.2 | -11.7 | -8.5 | -12.6 |
External localization resources
Images






























Protein Concentration and Protein Localization Data
| R1 | R2 | R3 | ||||||||||||||||
|---|---|---|---|---|---|---|---|---|---|---|---|---|---|---|---|---|---|---|
| G1 Pre-START | G1 Post-START | S/G2 | Metaphase | Anaphase | Telophase | G1 Pre-START | G1 Post-START | S/G2 | Metaphase | Anaphase | Telophase | G1 Pre-START | G1 Post-START | S/G2 | Metaphase | Anaphase | Telophase | |
| Concentration | 48.5284 | 63.3357 | 53.0609 | 53.4021 | 58.0337 | 56.3421 | 53.3456 | 68.6355 | 62.3133 | 61.3164 | 50.5274 | 61.6422 | 49.7074 | 61.7944 | 57.3575 | 53.3538 | 50.8469 | 57.9987 |
| Actin | 0.0295 | 0.0001 | 0.002 | 0.0003 | 0.0001 | 0.004 | 0.0103 | 0.0002 | 0.0034 | 0.003 | 0.001 | 0.0001 | 0.0131 | 0.0001 | 0 | 0.0412 | 0.0004 | 0.0002 |
| Bud | 0.002 | 0.0011 | 0.0004 | 0.0005 | 0 | 0.0001 | 0.0006 | 0.0001 | 0.0008 | 0.001 | 0.0011 | 0.0001 | 0.0017 | 0.0001 | 0.0001 | 0.0002 | 0.0004 | 0.0009 |
| Bud Neck | 0.0031 | 0.0001 | 0.0001 | 0.0001 | 0.0003 | 0.0004 | 0.0005 | 0.0001 | 0.0002 | 0.0003 | 0.0006 | 0.0005 | 0.0005 | 0.0001 | 0.0001 | 0.0006 | 0.0002 | 0.0004 |
| Bud Periphery | 0.0018 | 0.0003 | 0.0003 | 0.0004 | 0 | 0.0002 | 0.0005 | 0 | 0.0006 | 0.001 | 0.0021 | 0.0001 | 0.0012 | 0 | 0 | 0.0002 | 0.0003 | 0.0004 |
| Bud Site | 0.0081 | 0.0002 | 0.0003 | 0.0002 | 0 | 0 | 0.0024 | 0.0001 | 0.0019 | 0.0028 | 0.0007 | 0 | 0.0011 | 0 | 0.0001 | 0.0006 | 0.0003 | 0.0001 |
| Cell Periphery | 0.0009 | 0.0001 | 0.0003 | 0.0002 | 0.0001 | 0.0001 | 0.0005 | 0.0001 | 0.0001 | 0 | 0.0019 | 0.0001 | 0.0006 | 0.0001 | 0.0001 | 0.0002 | 0.0006 | 0.0001 |
| Cytoplasm | 0.0838 | 0.1706 | 0.0428 | 0.0855 | 0.1824 | 0.1111 | 0.1307 | 0.2405 | 0.1027 | 0.1352 | 0.2152 | 0.1928 | 0.1014 | 0.23 | 0.0887 | 0.0696 | 0.1303 | 0.1425 |
| Cytoplasmic Foci | 0.0104 | 0.0009 | 0.0147 | 0.0155 | 0 | 0.0007 | 0.0096 | 0 | 0.0037 | 0.0062 | 0.0052 | 0.0011 | 0.0082 | 0.0001 | 0.0064 | 0.0058 | 0.0027 | 0.0002 |
| Eisosomes | 0.0005 | 0 | 0.0001 | 0 | 0 | 0.0001 | 0.0002 | 0 | 0 | 0 | 0.0001 | 0 | 0.0001 | 0 | 0 | 0.0003 | 0.0001 | 0 |
| Endoplasmic Reticulum | 0.0016 | 0.0001 | 0.0004 | 0.0017 | 0.0001 | 0.0004 | 0.0034 | 0.0001 | 0.0009 | 0.0001 | 0.0046 | 0.0002 | 0.0023 | 0.0001 | 0.0001 | 0.0016 | 0.0009 | 0.0002 |
| Endosome | 0.0043 | 0 | 0.0059 | 0.0019 | 0 | 0.0005 | 0.0071 | 0 | 0.0014 | 0.0032 | 0.0178 | 0.0001 | 0.0053 | 0.0001 | 0.0001 | 0.0038 | 0.0012 | 0.0001 |
| Golgi | 0.003 | 0 | 0.0035 | 0.0004 | 0 | 0.0011 | 0.0028 | 0 | 0.0009 | 0.005 | 0.0015 | 0 | 0.0009 | 0 | 0 | 0.0025 | 0.0008 | 0 |
| Lipid Particles | 0.0116 | 0 | 0.004 | 0.0117 | 0 | 0.0009 | 0.0106 | 0 | 0.0009 | 0.0003 | 0.0042 | 0.0005 | 0.003 | 0 | 0.001 | 0.0134 | 0.0387 | 0 |
| Mitochondria | 0.0088 | 0.001 | 0.0126 | 0.0015 | 0.0001 | 0.0019 | 0.005 | 0.0005 | 0.0018 | 0.003 | 0.015 | 0.0007 | 0.0085 | 0.0003 | 0.001 | 0.0075 | 0.0259 | 0.0007 |
| None | 0.0019 | 0.0005 | 0.002 | 0.0045 | 0 | 0.0008 | 0.0098 | 0.0001 | 0.0026 | 0.0001 | 0.0056 | 0.0009 | 0.0053 | 0.0003 | 0.0022 | 0.0018 | 0.0047 | 0.0003 |
| Nuclear Periphery | 0.0288 | 0.0212 | 0.023 | 0.0264 | 0.0517 | 0.0333 | 0.0317 | 0.0176 | 0.0153 | 0.0121 | 0.0392 | 0.0263 | 0.0326 | 0.0231 | 0.0213 | 0.021 | 0.0359 | 0.0292 |
| Nucleolus | 0.0096 | 0.001 | 0.0106 | 0.0026 | 0.0013 | 0.0095 | 0.0151 | 0.0024 | 0.0016 | 0.0002 | 0.013 | 0.0093 | 0.0161 | 0.0026 | 0.0065 | 0.0025 | 0.0263 | 0.0011 |
| Nucleus | 0.7645 | 0.8015 | 0.8613 | 0.8348 | 0.7616 | 0.8294 | 0.7388 | 0.7372 | 0.8569 | 0.823 | 0.6231 | 0.764 | 0.7677 | 0.7406 | 0.8699 | 0.8194 | 0.7185 | 0.8219 |
| Peroxisomes | 0.0024 | 0.0001 | 0.0009 | 0.0005 | 0 | 0.0001 | 0.0041 | 0 | 0.0003 | 0.0029 | 0.0003 | 0 | 0.0007 | 0 | 0.0001 | 0.0008 | 0.0013 | 0 |
| Punctate Nuclear | 0.0054 | 0.0002 | 0.0023 | 0.007 | 0.0003 | 0.0024 | 0.0064 | 0.0004 | 0.0012 | 0.0003 | 0.0101 | 0.0016 | 0.0145 | 0.0006 | 0.0013 | 0.0014 | 0.0027 | 0.0005 |
| Vacuole | 0.0095 | 0.0008 | 0.0066 | 0.0023 | 0.0012 | 0.0013 | 0.007 | 0.0005 | 0.0017 | 0.0003 | 0.0237 | 0.001 | 0.0091 | 0.001 | 0.0006 | 0.0019 | 0.0037 | 0.0006 |
| Vacuole Periphery | 0.0086 | 0.0004 | 0.006 | 0.002 | 0.0008 | 0.0017 | 0.0032 | 0.0002 | 0.0008 | 0.0001 | 0.0139 | 0.0007 | 0.0062 | 0.0006 | 0.0006 | 0.0037 | 0.0042 | 0.0004 |
Sequencing Data
| R1 | R2 | |||||||||
|---|---|---|---|---|---|---|---|---|---|---|
| G1 Post-START | S/G2 | Metaphase | Anaphase | Telophase | G1 Post-START | S/G2 | Metaphase | Anaphase | Telophase | |
| Gene Expression | 243.2872 | 229.0317 | 258.9736 | 278.8406 | 238.668 | 237.4144 | 278.1966 | 294.9717 | 316.1156 | 304.8541 |
| Translational Efficiency | 1.4728 | 1.5528 | 1.4569 | 1.5567 | 1.469 | 1.4568 | 1.4022 | 1.2422 | 1.335 | 1.3002 |
Hit Data
| Dataset | Hit |
|---|---|
| Protein Concentration | ✘ |
| Protein Localization | ✘ |
| Gene Expression | ✔ |
| Translational Efficiency | ✘ |
Endocytosis
| Temp | Actin Patch (Sac6-tdTomato) | Cortical Patch (Sla1-GFP) | Late Endosome (Snf7-GFP) | Vacuole (Vph1-GFP) |
|---|---|---|---|---|
| 37℃ | ||||
| RT |
Cell Cycle Omics
CYCLoPs (Uba1-GFP)
| Gene / Allele | Actin Patch (Sac6-tdTomato) | Cortical Patch (Sla1-GFP) | Late Endosome (Snf7-GFP) | Vacuole (Sac6-tdTomato) |
|---|
| Gene | Images |
|---|
| Gene | Images |
|---|
Images are not yet available
Images are not yet available